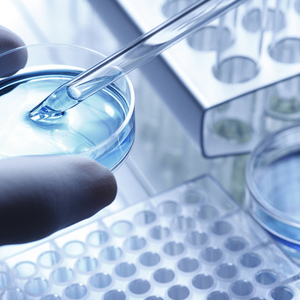

界面新闻记者 |
界面新闻编辑 | 翟瑞民
2023年8月31日,中国科学院和中国工程院官网同时发布院士增选有效候选人名单。其中,中国科学院增选有效候选人为583人,中国工程院增选有效候选人为655人。
从目前公布的两院增选有效候选人名单来看,2023年院士入选竞争较为激烈。中国工程院此前发布的院士增选指南介绍,今年院士增选总名额将不超过90名。中国科学院发布院士增选指南介绍,今年中国科学院院士增选名额共79名。
根据名单,候选人年龄最小的为来自中国人民解放军军事科学院国防科技创新研究院的常超,39岁。其主要研究方向为高功率微波(HPM)介质窗击穿机理研究及其应用,提出了周期性表面和谐振磁场抑制微波倍增和击穿的方法,突破了高功率微波系统功率容量的技术瓶颈。
公开资料显示,常超先后主持参与国家重点研发计划项目、国家基础加强重点项目、国家卓越青年基金项目、国家自然科学基金优秀青年基金项目、国家自然科学基金面上项目等10余项,曾获2019国家自然科学二等奖(第一),省部级科技进步一等奖两项,IEEE NPSS Early Achievement Award、陈嘉庚青年科学奖、亚太等离子体物理青年学者奖等。发表 SCI 论文 60 篇,出版专著1 部,获授权发明专利20件。
据中国青年报2022年报道,当年,常超出国深造,如果留在国外发展,收入可能是现在的10倍以上。“诱惑是客观存在的。”常超坦言,但他也很清楚,在国外,发展的天花板会很快到来,“因为华人永远进不了那个最核心的圈层”。

常超曾说,“在这里(军事科学院),我能真真切切感受到,是在为自己的国家做事。”这种“感觉”,是无论多少钱都买不来的。
在候选人名单中,年龄最大的是山河智能装备股份有限公司创始人何清华,77岁,推荐人为王振国、项昌乐。
公开资料显示,何清华于1946年3月出生,1980年自学直接考上中南大学机械学科的第一个研究生,进而成为中南大学机电学科教授,并在1999年创办了山河智能装备股份有限公司,经过20余年的发展,该公司已成为跻身于全球工程机械制造商50强的高端产学研一体化名企。
同样出生于1946年的还有来自上海交通大学的谭家华,他是我国最早开展海上施工设备与特殊装备技术研究的专家之一,研发的大型绞吸挖泥船是高效建设远海岛礁、港口、航道等的必要装备。他2004年带领团队自主设计建造了国内首艘大型绞吸挖泥船“航绞2001”, 打破了我国绞吸挖泥船完全依赖进口的局面。
抗击新冠疫情以来,医疗界专家学者受到广泛关注。界面新闻注意到,在今年院士增选候选人名单中,中日友好医院副院长曹彬、中国科学院武汉病毒研究所研究员石正丽,都名列其中。
曹彬是我国著名呼吸与危重症医学家,被誉为“中国呼吸学科领军人”,曾获得国家科学技术进步奖特等奖。2020年初,武汉新冠疫情发生后,曹彬是第一批抵汉的国家卫健委医疗组专家成员。石正丽系武汉病毒研究所新发传染病研究中心主任、生物安全工作委员会主任、新发病毒学科组组长。石正丽被外界誉为“蝙蝠女侠”,因其在SARS病毒溯源的研究中证实了蝙蝠是SARS冠状病毒的自然宿主。
此外,来自清华大学的颜宁再次入选院士增选有效候选人。颜宁是著名结构生物学家、美国国家科学院外籍院士,现任深圳医学科学院(筹)院长、深圳湾实验室主任。她主要致力于跨膜运输蛋白的结构与机理研究,在国际上首次揭示人源葡萄糖转运蛋白、真核生物电压门控钠离子通道和钙离子通道等一系列具有重要生理与病理意义跨膜蛋白的原子分辨率结构,为理解相关疾病的致病机理及药物开发提供了分子基础。
2007年7月,不满30岁的普林斯顿大学博士颜宁,受聘清华大学医学院教授,成为清华大学当时最年轻的教授、博士生导师。2017年,她接受美国普林斯顿大学邀请,受聘普林斯顿大学分子生物学系雪莉·蒂尔曼终身讲席教授的职位。
2022年,颜宁“二次回国”,辞去普林斯顿大学教职,加盟深圳医学科学院。“近年来我愈发感觉到,在实验室育人、看到一代代的年轻人在接受我的科研指导之后去拓展自己的一片天空,做出更多成果、培养下一代科学家,那种传承的成就感甚至已经超越了我自己做出科研突破的快乐。”颜宁在2022年接受红星新闻采访时表示。
中国两院院士增选每两年进行一次。2021年,中国工程院和中国科学院曾进行一次院士增选,其中,中国工程院增选院士84人,中国科学院增选院士65人。增选后,中国工程院院士总数为971人,外籍院士总数为111人;中国科学院院士总数为860人,外籍院士总数为129人。